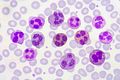

VIETNAMESE
bạch cầu
ENGLISH
leukocytes
/ˈlukəˌsaɪts/
Bạch cầu là một loại tế bào của máu, không màu và có chức năng chống lại vi khuẩn gây bệnh.
Ví dụ
1.
Bạch cầu là tế bào của hệ thống miễn dịch, nhằm bảo vệ cơ thể chống lại những dị vật xâm nhập.
Leukocytes are the cells of the immune system that protect the body against foreign invaders.
2.
Các bạch cầu tích tụ và làm trầm trọng thêm tình trạng viêm.
The leukocytes pile up, creating and worsening the inflammation.
Ghi chú
Chúng ta cùng học các từ tiếng Anh để nói về các thành phần trong máu nha!
- red blood cells (hồng cầu)
- leukocytes (bạch cầu)
- platelet (tiểu cầu)
- blood plasma (huyết tương)
Danh sách từ mới nhất:
Xem chi tiết



